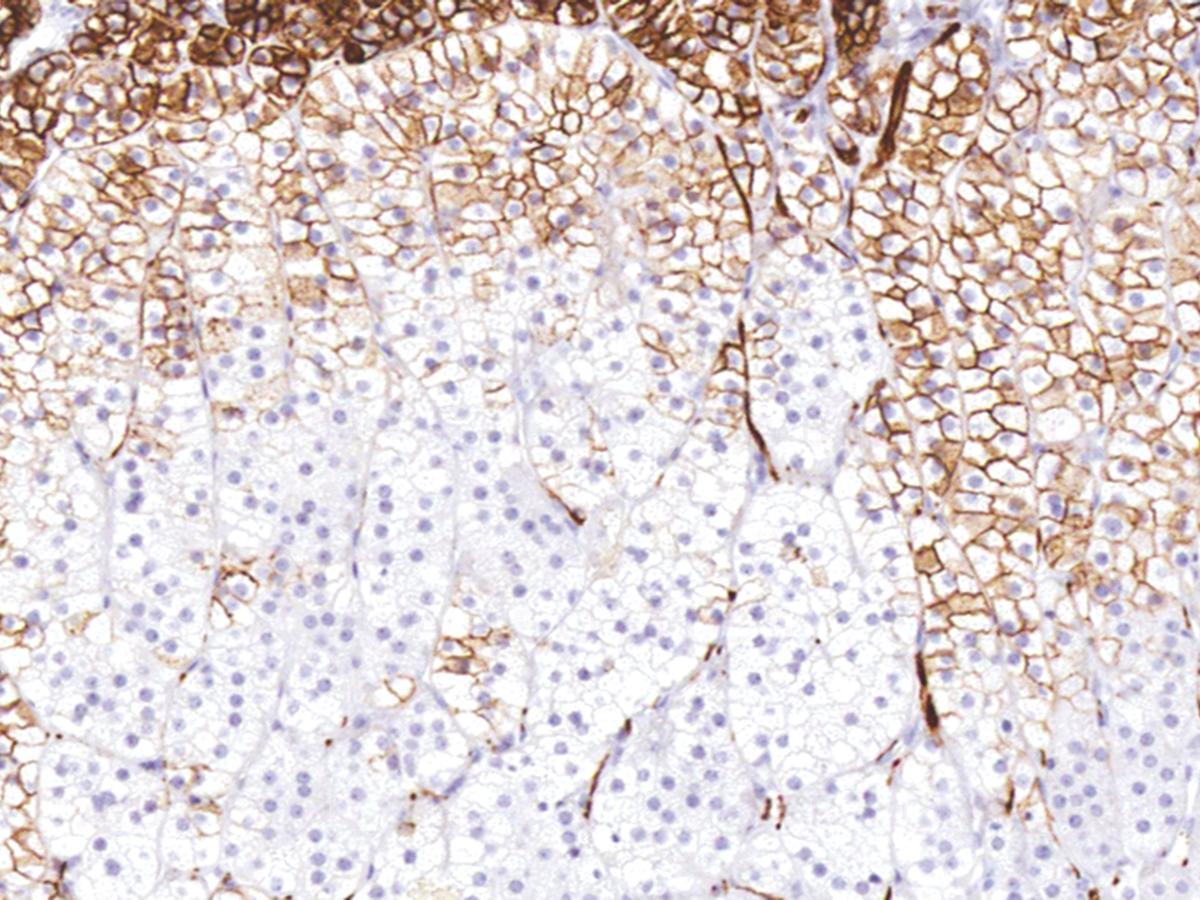

Anti-CD56 Monoclonal Antibody (Clone:IHC056)(Discontinued)
Shipping Info:
For estimated delivery dates, please contact us at [email protected]
| Format : | Purified |
| Amount : | 1 ml |
| Purification : | Protein A/G Chromatography |
| Storage condition : | Store at 2°C - 8°C. |
Cluster of differentiation 56 (CD56), also known as Neural-Cell Adhesion Molecule (NCAM), is a glycoprotein involved in synaptic plasticity, cell-cell adhesion, neurite outgrowth, learning, and memory. NCAM is expressed in normal neurons, glia, natural killer cells, activated T-cells, brain and cerebellum, neuroendocrine tissues, and skeletal muscle. Anti-CD56 recognizes a number of tumors including myeloma, myeloid leukemia, natural killer/T-cell lymphomas, neuroendocrine tumors, pancreatic acinar-cell carcinoma, pheochromocytoma, and WilmÂ’s tumor. CD56 is detectable in neoplasms that are neuroectodermally-derived, such as retinoblastoma, medulloblastomas, astrocytomas, small cell carcinomas, and neuroblastomas. It has also been linked to rhabdomyosarcoma, a tumor that is mesodermally-derived.
Recommended dilutions: Immunohistochemical analysis: 1:100 - 1:200. However, this need to be optimized based on the research applications.
For Research Use Only. Not for use in diagnostic/therapeutics procedures.
|
There are currently no product reviews
|

.png)











